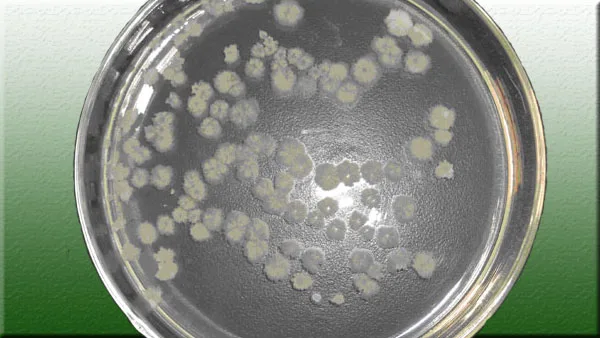
Биологический фунгицид для контроля насекомых и вредных бактерий

Биологический фунгицид для контроля насекомых и вредных бактерий
- Category: Biological Fertilizer >>>
- Supplier: Hebei New Century Zhoutian Biotechology Co. Ltd.
Share on (62407234306):
Product Overview
Description

Biological fungicide for control the plant insect and harmful bacteria
Biological disinfection agentia and insecticide is combined with the Compound Microorganism Bacterium Agent, cosolvent, synergist, stabilizer and the surface active agent.
It was a fast effect ,high effect and widely used biological disinfection agentia and insecticide, it was lower toxicity,and no residue,hamless and safe for the human and the livestock.
It can control the hard water and the grease, it also have good stability.
Active ingredients:
bacillus, lactic acid bacteria, Compound Microorganism Bacterium Agent, cosolvent, synergist, stabilizer and the surface active agent
Living bacteria count ≥0.5billion/gram
Functions:
It have good effect for kill the parasite, piercing and sucking insects:such as the scale insect,
plant hopper, borer, flatheaded borer, Blind stink bug, aphid, cutworm, root-knot nematode, Cicadas class and sphingid.
High efficiency Insecticidal, the pharmacologic action of this product is mainly as contact toxicity,both have the effect of stomach toxicity and repellant.
It also have the function of kill the Worm eggs,only use one time will eradicate one generation mite Bug
The effect could last at least two months
Use method:
1. Before use this product it will need add water for dilution
2. Use the diluents for spaying,root irrigation or inunction,
3. Be assured that all the diluents have been wet through,it will be better that the Wetting degree is advisable for liquid drops, Effective use of concentration are as follows:
3.1 aphid, plant hopper,sphingid,add water 2000-3000 times
3.2 scale insect,red spider,flatheaded borer, borer insect,blind stink bug add 1500-2000 times water
3.3 agrotis ypsilon, mole cricket,root-knot nematode,add water 500-800 times for root irrigation or add this product 7.5-15KG per HA with 300-450 silver sand for Bottom application.
[Notes]
1. When dilute the water temperature will be better around 20℃ if the temperature above 50℃, bacterium suspension will disintegrate and lose efficacy
2. Do not use the alkaline water to dilute, and do not use together with the alkaline drug, in case the bacterium suspension lose efficacy
3. After be dilute, the bacterium suspension have better stabilization, seal and avoid direct sunlight, it will have efficacy within one month and could be used as usual
[Packing]100g/bag,60bag×100g/piece
shelf life, 2 years.







We Recommend
New Arrivals
New products from manufacturers at wholesale prices